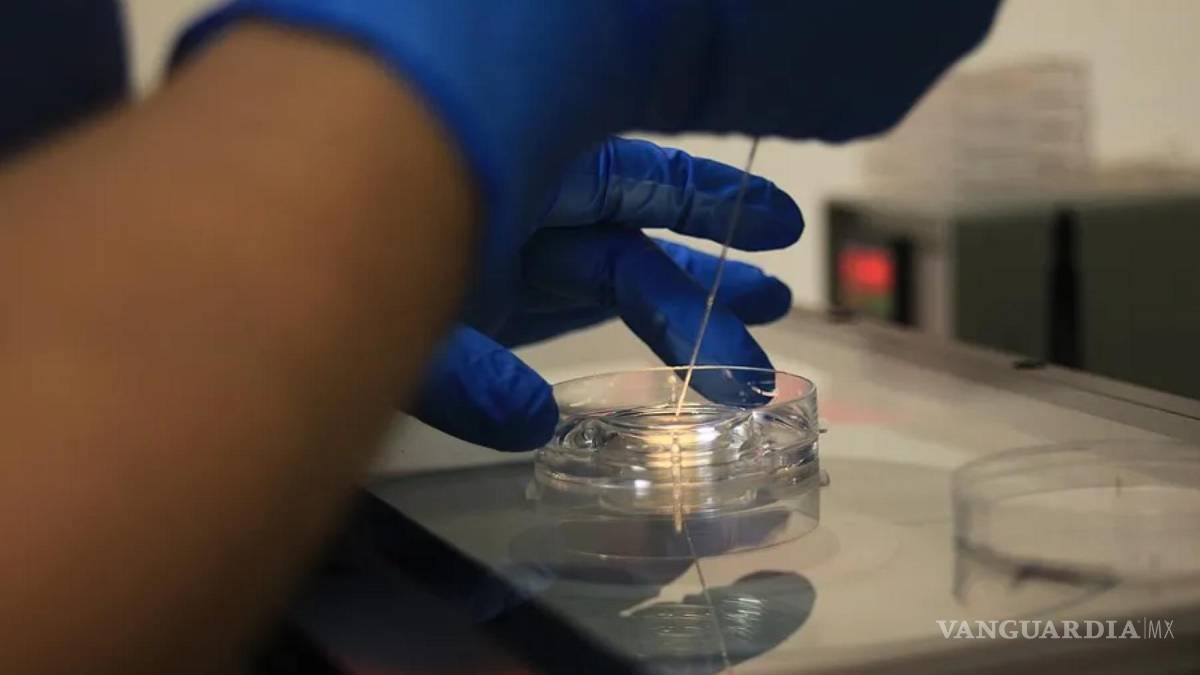

Un equipo de científicos encontró hasta ocho polímeros distintos en el semen humano
COMPARTIR
Un equipo científico chino ha encontrado microplásticos, hasta ocho polímeros distintos, en 40 muestras de semen, identificándose ocho polímeros distintos, siendo el poliestireno en un 31 % el más prevalente
CHINA- Las conclusiones de este nuevo estudio, fueron publicadas en la revista Science of The Total Environment.
De acuerdo con el articulo “Prevalence and implications of microplastic contaminants in general human seminal fluid: A Raman spectroscopic study”, los microplásticos son contaminantes ambientales omnipresentes que fueron encontrados en el semen humano en áreas contaminadas, sin embargo, precisan Ning Li, Huijun Yang, Yunling Dong, Bin Wei, Liyang Liang, Xiang Yun, Jiaqi Tian, Yongfei Zheng, Shuyin Duan y Lin Zhang autores de esta investigación, “su prevalencia y efectos en la población general siguen en gran medida inexplorados”.
TE PUEDE INTERESAR: Por primera vez un estudio precisa que hay 11 millones de toneladas de plástico cubren el fondo marino
Para poder examinar tanto la presencia, como la abundancia, así como los tipos de polímeros y asociaciones de microplásticos “con parámetros de calidad del semen en individuos sin exposición ocupacional”, este estudio se realizó a través de la recolección muestras de semen de 40 voluntarios que participaron en esta investigación que se sometieron a evaluaciones de salud prematrimoniales en Jinan, China.
Para llevar a acabo el análisis de las muestras, los autores usaron lo que se conoce como la microespectroscopia Raman con el propósito de poder “identificar, cuantificar y categorizar polímeros microplásticos”, así como también “la motilidad de los espermatozoides se evaluó mediante análisis asistido por computadora y la morfología se evaluó mediante tinción Diff-Quik”.
Por medio de un análisis estadístico, los autores, analizaron las correlaciones entre los datos demográficos, así como los parámetros del semen y el contenido de microplásticos.

Los investigadores de la Universidad de Qingdao descubrieron la existencia de microplásticos en todas las muestras de semen, con dos partículas por muestra.
TE PUEDE INTERESAR: Hay alrededor de 250, 000 partículas de nanoplásticos en un litro de agua embotellada, señalan científicos
IDENTIFICAN OCHO POLÍMEROS DISTINTOS
Tras su análisis, los autores lograron identificar ocho polímeros distintos, siendo el poliestireno con el 31 %, el polietileno en un 14 %) y el cloruro de polivinilo (PVC), con el 14 % los más prevalentes.
El semen expuesto al poliestireno reflejó una mayor motilidad progresiva de los espermatozoides en comparación con el grupo expuesto al cloruro de polivinilo. Así mismo, los autores descubrieron anomalías morfológicas en los espermatozoides, sin embargo fueron asociaron significativamente a tipos de plástico específicos.
“Se observaron anomalías morfológicas del esperma, pero no se asociaron significativamente con tipos de plástico específicos. En conclusión, este estudio revela contaminación por microplásticos en el semen de individuos sin exposición ocupacional, siendo PS, PE y PVC los más prevalentes y exhiben correlaciones diferenciales con la motilidad progresiva de los espermatozoides, y resalta la necesidad de realizar más investigaciones sobre los posibles impactos reproductivos de los microplásticos. exposición”, explican los autores.
¿CÓMO AFECTA A LA FERTILIDAD MASCULINA?
Los autores precisan que si bien, anteriores estudios apuntan a que la exposición a microplásticos puede originar inflamación y estrés oxidativo en los sistemas gastrointestinal y respiratorio, sin embargo, los efectos de estos en la reproducción y la fertilidad “aún no están claros”.
A nivel mundial, citan los autores, cerca del 15 % de las parejas presentan infertilidad, en la que en los hombres es del el 50 % de los casos, además de la infertilidad masculina se incrementó “junto con el deterioro de la calidad del semen en las últimas décadas”.
Por otra parte, señalan los autores, que “la causa de la alteración de la espermatogénesis sigue sin identificarse en aproximadamente el 40 % de los hombres”. y añaden que este padecimiento “ocurre en los túbulos seminíferos de los testículos, que consisten en epitelio espermatogénico y células de Sertoli”.
Además, precisan que de acuerdo a “la evidencia anterior muestra que los microplásticos pueden dañar la barrera hematotesticular y afectar la calidad del esperma en modelos animales”
Sin embargo, precisan los autores, se requiere llevar a cabo más investigaciones para poder tener claro “los posibles impactos reproductivos de los microplásticos en humanos”.
“En este estudio, utilizamos un microscopio Raman confocal para identificar y categorizar microplásticos en el semen humano en general, dilucidando su presencia, abundancia y tipos de polímeros y comparando la alteración de los parámetros del esperma entre diferentes polímeros plásticos. Estos datos contribuirían a aclarar las implicaciones de la exposición a los microplásticos para la producción de esperma y arrojarían luz sobre un posible factor ambiental del deterioro de la salud reproductiva masculina en todo el mundo”, detallan los autores.
Si bien la ciencia lleva estudiando desde hace décadas el efecto de la contaminación por microplásticos en la salud humana y cómo estos residuos terminan penetrándose en el cuerpo y con ellos los tóxicos que puedan contener; aún queda mucho por saber, por ahora algunas evidencias apuntan a que su presencia en la placenta y en la leche materna, así como el torrente sanguíneo, además en los pulmones o en el cerebro.
Los autores concluyen que de “todas las muestras de semen analizadas en este estudio contenían microplásticos, siendo el PS el más frecuente entre los ocho polímeros identificados”, y concluyen explicando que “si bien los efectos de la exposición a diferentes polímeros microplásticos sobre la motilidad progresiva de los espermatozoides variaron, lo que subraya la necesidad de seguir investigando cómo los microplásticos afectan la fertilidad masculina en términos de su presencia generalizada y su posible toxicidad reproductiva”.
Con información de la Agencia EFE y Science of The Total Environment.








